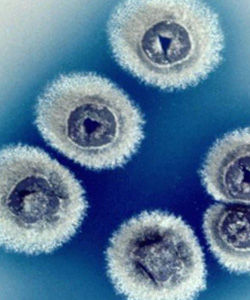
天藍色鏈黴菌

基本資料
天藍色鏈黴菌屬名:Streptomyces
種名:coelicolor
具體用途:分類學研究。
培養基:331
培養溫度:28℃
基因特徵
天藍色鏈黴菌(Streptomyces coelicolor)基因組,也是迄今最大的微生物基因組的測序工作,該基因組中蘊藏著令人驚奇而又大有前途的基因組特徵。現在,科學家們力圖將該細菌轉化成更佳的藥物開發工具。
天藍色鏈黴菌是生產三分之二用於醫藥的天然抗生素以及共9000餘種具生物活性物質的鏈黴菌大家族中的一員。不同於其它種類的細菌,鏈黴菌長成細絲狀菌落,象多細胞生物體一樣發育出專門的“組織”。鏈黴菌繁殖前,會生產出更多的抗生素以抵禦競爭者。這恰恰是科學家想要針對抗藥性細菌所採用的策略。
科學研究
來自英國John Innes中心和Sanger研究院的研究人員徹底探查S. coelicolor的基因組後,共發現7825個可疑基因。有關S. coelicolor基因組的分析研究發表在5月9日期的《自然》雜誌上,文章還描繪了3種迄今未知抗生素的裝配線藍圖,這3種抗生素一旦被識別,就可作為藥物開發中的啟動化合物。
該鏈黴菌的基因組序列還為研究人員了解鏈黴菌的生活方式提供了新的線索。不同尋常的是,天藍色鏈黴菌許多基因編碼的是有助於運輸材料進出細胞的蛋白質,這使得天藍色鏈黴菌成為可以應付多種土壤條件和食物來源的“多面手”。也許最令人驚異的當屬發現了一組正常條件下編碼用於形成氣囊(gas vesicle)蛋白的基因,氣囊通常被水生細菌用作產生浮力。John Innes中心研究S. coelicolor已有40多年歷史的退休教授David Hopwood認為,編碼氣囊蛋白基因的發現是“最最奇妙的事情。”他推測,氣囊有助於鏈黴菌的孢子生存於富氧的濕地土壤表面。
John Innes中心的另一位研究人員Mark Buttner現在正協調一項230萬美元的研究項目,旨在把天藍色鏈黴菌轉化成藥物開發的有效工具。他表示,經過特別設計的鏈黴菌株系可以使研究人員將鏈黴菌以及其它細菌生產的各種基礎抗生素結合起來,製成新型的混合抗生素。
盤點世界上的微生物(六)
| 微生物是包括細菌、病毒、真菌以及一些小型的原生動物、顯微藻類等在內的一大類生物群體,它個體微小,卻與人類生活關係密切。涵蓋了有益有害的眾多種類,廣泛涉及健康、食品、醫藥、工農業、環保等諸多領域。 |
盤點質控菌株(三)
| 要搞好臨床微生物學檢驗質控,必須保存有一批標準菌株,作為對儀器、培養基、染色液、試劑和診斷血清的質控菌株,也可作為從事細菌檢驗的工作人員熟悉某些菌株的教具。 |